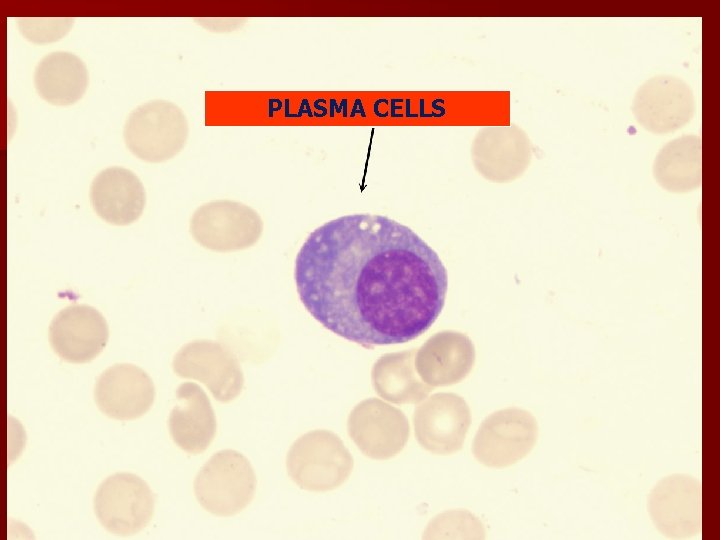

CONNECTIVE TISSUE Connective tissue It is characterized by

CONNECTIVE TISSUE

Connective tissue Ø It is characterized by cells and intercellular substance. Ø Intercellular substance is abundance in c. t , so cells are widely separated.

Components of C. T. Ø CONNECTIVE TISSUE CELLS. Ø CONNECTIVE TISSUE FIBERS. Ø GROUND SUBSTANCE.

CELLS n n n n FIBROBLASTS. MACROPHAGES (HISTEOCYTES). MAST CELLS PLASMA CELLS FAT CELLS. PIGMENT CELLS. LYMPHOCYTES , EOSINOPHILS UNDIFFERENTIATED MESENCHYMAL CELLS.

INDIVIDUAL CELLS OF C. T.

FIBROBLASTS

Fibroblasts. Connective tissue where parallel bundles of collagen are being formed. (a): Fibroblasts typically show large active nuclei and eosinophilic cytoplasm tapering off in both directions along the axis of the nucleus, a morphology usually called “spindle— shaped. ” The nuclei (arrows) are clearly seen, but the cytoplasmic processes resemble the collagen bundles (C) that fill the extracellular matrix and are difficult to distinguish in H&E—stained sections

A connective tissue layer (dermis) shows several fibroblasts (F), which are the elongated cells.

MACROPHAGES IRREGULAR SHAPE , NUCLEUS IS SMALLER AND ROUNDED. ØBIG EATER ØMULTINUCLEATED FOREIGN BODY GIANT CELLS

ØBIG EATER

MULTINUCLEATED FOREIGN BODY GIANT CELLS

multinuclear giant cells

ØOVOID CELLS. ØECENTRICAL NUCLEUS. ØCLOCK –FACE OR CART WHEEL APPEARANCE. ØLIGHT CYTOPLASMIC AREA NEAR THE NUCLEUS. ØANTIBODIES PLASMA CELLS

Portion of a chronically inflamed intestinal villus. The plasma cells are characterized by their size and abundant basophilic cytoplasm (rough endoplasmic reticulum) and are involved in the synthesis of antibodies.
PLASMA CELLS

MAST CELLS

Ø LARGE OVOID CELLS WITH SMALL OVAL NUCLEI. Ø CONTAINS HEPARIN AND HISTAMINE GRANULES. Ø RESISTS THE SPREAD OF INFECTION.


Section of rat tongue. Several mast cells in the connective tissue surround muscle cells and blood

FAT CELLS

PIGMENT CELLS

CONNECTIVE TISSUE FIBERS n COLLAGENOUS n ELASTIC FIBERS. n RETICULAR FIBERS.

Parameters Collagen fibers Elastic fibers Appearance white yellow Diameter Broader 2 -10 um thinner Pattern wavy Shiny single fiber Reticular fiber Source of formation Fibroblasts, osteoblasts, Chondroblast. reticular cells. Reticulocytes. Protein Collagen type 1 Elastin Fibroblasts In aorta by smooth muscles. black Thinnest. Single branched fibers (net). Fibroblasts. Reticulin (collagen type 111)

parameters CHO content Flexibility Staining (H&E) Collagen Little Stretchable until become straight. EOSINOPHLIC DISTRIBUTION n. TENDONS n. LIGAMENTS n. CARTILAGE n. BONE n. CORNEA Elastic Little Stretchable like rubber. Reticular More Flexible like collagen. WEAK EOSINOPHILIC UN STAINED n. ELASTIC n. ENDOMETRIUM ARTERIES n. ELASTIC CARTILAGES. n. IN frame work of spleen, lymph node, glands.

Collagen fibers

Elastic fibers

Section of an adrenal cortex, silver stained to show reticular fibers.

Reticular fibers

Ground substance Ø Cells and fibers are embedded in it. Ø It is in the form of gel of variable viscosity. Ø It consists of proteoglycans v Glycosaminoglycans v Hyaluronic acid

Ground substance Ø Glycoproteins v Fibrilin v Fibronectin v Chondronectin v Laminin Ø Medium for diffusion of gases and metabolic substances.
- Slides: 30